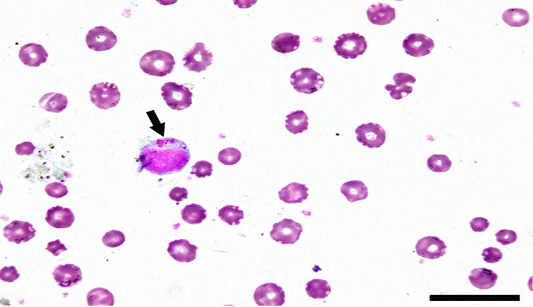

The Journal of Advances in Parasitology
Clinical symptoms of theileriosis in examined Balady-Friesian cattle in Egypt. a) The perineal area of an infected animal heavily infected with tick species. b) An eye of Theileria-infected cattle showing ticks infestations. c) Severe bovine ocular affections. d) Enlargement of superficial lymph nodes
Bovine lymphocytes infected with Theileria parasites. Arrow referred to macroschizont. Scale bar= 20 µm
PCR amplification of DNA extracted from blood specimens of Theileria-infected cattle using the specific primer pair, Cytob1, targeting the mitochondrial cytochrome b gene. Note the diagnostic band appeared as 312 bp. Lane M revealed 100-bp ladder= DNA marker. Lanes 1-10 indicated 10 positive animals (animals are numbered as 23, 44, 56, 60, 76, 85, 91, 92, 93 and 98, respectively). Lanes 11 and 12 indicated negative animals (animals numbered 18 and 79)